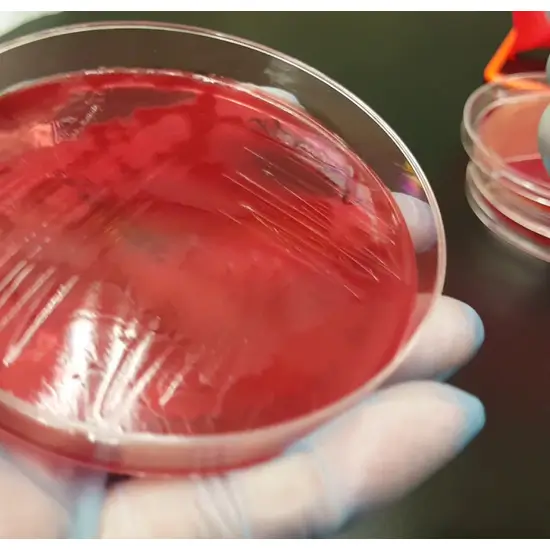

Book Culture Clostridium Test Appointment Online Near me at the best price in Delhi/NCR from Ganesh Diagnostic. NABL & NABH Accredited Diagnostic centre and Pathology lab in Delhi offering a wide range of Radiology & Pathology tests. Get Free Ambulance & Free Home Sample collection. 24X7 Hour Open. Call Now at 011-47-444-444 to Book your Culture Clostridium Test at 50% Discount.
Book Culture Clostridium Test at the best price in Delhi NCR, India from GDIC (Ganesh Diagnostic & Imaging Centre). GDIC is a NABL Accredited Pathology lab in Delhi offering a wide range of lab testing services.
What is Culture Clostridium Test?
This is a test that looks for harmful substances called toxins produced by the Clostridioides (formerly Clostridium) difficile bacteria in your bowel movement (stool).
Other Names:
Clostridioides Difficile Toxin (Stool)
Why it is done?
If you have any of the following symptoms, especially if you are in the hospital or have recently taken antibiotics, you may require this test:
Constipation This entails at least three loose stools per day for at least two days.
You have blood or mucus in your stool.
Constant constipation can cause stomach pain, nausea, loss of appetite, and fever.
What is the procedure for Culture Clostridium Test?
A stool sample is required for this test. Your doctor will show you how to collect a sample in a disposable specimen container with a lid. Do not collect stool or toilet paper from the toilet bowl or place it in the specimen container.
How does one prepare for the test?
No preparation is needed.
Required Documents for
After Care:
No care is required.
The Cost Of Culture Clostridium Test In Delhi:
The Culture Clostridium Test costs vary by region and facility. So, get tested at trustworthy diagnostic centre like Ganesh Diagnostic. Training and experienced professionals are staffed to assure patient and visitor safety.
| Test Type | Culture Clostridium Test |
| Includes | Culture Clostridium - lab tests |
| Preparation | |
| Reporting | Within 24 Hours*. |
| Test Price |
₹ 630
|

Early check ups are always better than delayed ones. Safety, precaution & care is depicted from the several health checkups. Here, we present simple & comprehensive health packages for any kind of testing to ensure the early prescribed treatment to safeguard your health.